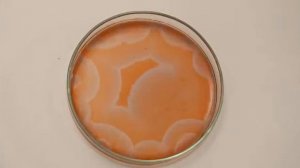
Ещё одна колебательная реакция Белоусова Жаботинского

0:30
0:30
2024-11-14 01:58

 3:30
3:30

 3:30
3:30
2024-11-12 02:09

 3:56
3:56

 3:56
3:56
2025-08-26 10:37

 5:24
5:24

 5:24
5:24
2025-09-12 06:00

 6:14
6:14

 6:14
6:14
2025-08-22 09:00

 1:11
1:11

 1:11
1:11
2025-09-22 05:01

 0:27
0:27

 0:27
0:27
2025-09-23 20:02

 41:08
41:08

 41:08
41:08
2025-09-26 10:59

 14:38
14:38

 14:38
14:38
2025-09-04 14:51

 0:30
0:30

 0:30
0:30
2025-09-17 10:00

 2:32
2:32

 2:32
2:32
2025-08-26 08:30

 5:54
5:54

 5:54
5:54
2025-09-21 11:00

 13:20
13:20

 13:20
13:20
2025-09-03 21:34

 2:08
2:08

 2:08
2:08
2025-09-03 12:24

 2:52
2:52

 2:52
2:52
2025-09-18 18:40

 0:49
0:49

 0:49
0:49
2025-09-11 14:43

 23:01
23:01

 23:01
23:01
2025-08-25 06:26

 13:29
13:29
![NAIMAN - Плакала (Премьера клипа 2025)]() 2:21
2:21
![Рустам Нахушев - Письмо (Лезгинка) Премьера клипа 2025]() 3:27
3:27
![Бунёд Бобокулов - Отам-онам (Премьера клипа 2025)]() 4:00
4:00
![Леся Кир - Альфонс (Премьера клипа 2025)]() 3:23
3:23
![Владимир Ждамиров, Игорь Кибирев - Тик так (Премьера 2025)]() 3:30
3:30
![Ахрор Гуломов - Ёмгирлар (Премьера клипа 2025)]() 3:49
3:49
![Динара Швец - Нас не найти (Премьера клипа 2025)]() 3:46
3:46
![Жамоладдин Аматов - Окибат (Премьера клипа 2025)]() 4:38
4:38
![Абрикоса, GOSHU - Удали из памяти (Премьера клипа 2025)]() 4:59
4:59
![Ozoda - Chamadon (Official Video 2025)]() 5:23
5:23
![Рузибек Кодиров - Бинафша (Премьера клипа 2025)]() 3:31
3:31
![Zhamil Turan - Губки не целованы (Премьера клипа 2025)]() 2:37
2:37
![Enrasta - Франция (Премьера клипа 2025)]() 2:44
2:44
![Инна Вальтер - Татарский взгляд (Премьера клипа 2025)]() 3:14
3:14
![Шохжахон Раҳмиддинов - Арзон (Премьера клипа 2025)]() 3:40
3:40
![Ксения Рат - Этажи (Премьера клипа 2025)]() 2:37
2:37
![Даша Эпова - Мой любимый человек (Премьера клипа 2025)]() 2:11
2:11
![ARTEE - Ты моя (Премьера клипа 2025)]() 3:31
3:31
![Маша Шейх - Будь человеком (Премьера клипа 2025)]() 2:41
2:41
![ZIMMA - Город Тает (Премьера клипа 2025)]() 2:30
2:30
![Пойман с поличным | Caught Stealing (2025)]() 1:46:45
1:46:45
![Рок-н-рольщик | RocknRolla (2008) (Гоблин)]() 1:54:23
1:54:23
![Стив | Steve (2025)]() 1:33:34
1:33:34
![Трон: Арес | Tron: Ares (2025)]() 1:52:27
1:52:27
![Вальсируя с Брандо | Waltzing with Brando (2024)]() 1:44:15
1:44:15
![Терминатор 2: Судный день | Terminator 2: Judgment Day (1991) (Гоблин)]() 2:36:13
2:36:13
![Порочный круг | Vicious (2025)]() 1:42:30
1:42:30
![Убойная суббота | Playdate (2025)]() 1:34:35
1:34:35
![Девушка из каюты №10 | The Woman in Cabin 10 (2025)]() 1:35:11
1:35:11
![Дом из динамита | A House of Dynamite (2025)]() 1:55:08
1:55:08
![Цельнометаллическая оболочка | Full Metal Jacket (1987) (Гоблин)]() 1:56:34
1:56:34
![Французский любовник | French Lover (2025)]() 2:02:20
2:02:20
![Фантастическая четвёрка: Первые шаги | The Fantastic Four: First Steps (2025)]() 1:54:40
1:54:40
![Большой Лебовски | The Big Lebowski (1998) (Гоблин)]() 1:56:59
1:56:59
![Школьный автобус | The Lost Bus (2025)]() 2:09:55
2:09:55
![Свайпнуть | Swiped (2025)]() 1:50:35
1:50:35
![Франкенштейн | Frankenstein (2025)]() 2:32:29
2:32:29
![Только ты | All of You (2025)]() 1:38:22
1:38:22
![Код 3 | Code 3 (2025)]() 1:39:56
1:39:56
![Однажды в Ирландии | The Guard (2011) (Гоблин)]() 1:32:16
1:32:16
![Новогодние мультики – Союзмультфильм]() 7:04
7:04
![Котёнок Шмяк]() 11:04
11:04
![Последний книжный магазин]() 11:20
11:20
![Корги по имени Моко. Новый питомец]() 3:28
3:28
![Сборники «Простоквашино»]() 1:05:35
1:05:35
![Неодети]() 11:27
11:27
![Команда Дино Сезон 2]() 12:31
12:31
![Забавные медвежата]() 13:00
13:00
![Команда Дино. Исследователи Сезон 2]() 13:26
13:26
![Папа Супергерой Сезон 1]() 4:28
4:28
![Панда и петушок Лука]() 12:12
12:12
![Тодли Великолепный!]() 3:15
3:15
![Корги по имени Моко. Защитники планеты]() 4:33
4:33
![Тёплая анимация | Новая авторская анимация Союзмультфильма]() 10:46
10:46
![Истории Баданаму Сезон 1]() 10:02
10:02
![Тайны Медовой долины]() 7:01
7:01
![Сборники «Зебра в клеточку»]() 45:30
45:30
![Команда Дино. Исследователи Сезон 1]() 13:10
13:10
![МиниФорс]() 0:00
0:00
![Карли – искательница приключений. Древнее королевство]() 13:00
13:00

 13:29
13:29Скачать Видео с Рутуба / RuTube
| 192x144 | ||
| 480x360 | ||
| 640x480 |
 2:21
2:21
2025-11-18 12:25
 3:27
3:27
2025-11-12 14:36
 4:00
4:00
2025-11-21 13:29
 3:23
3:23
2025-11-19 11:51
 3:30
3:30
2025-11-13 11:12
 3:49
3:49
2025-11-15 12:54
 3:46
3:46
2025-11-12 12:20
 4:38
4:38
2025-11-11 17:38
 4:59
4:59
2025-11-15 12:21
 5:23
5:23
2025-11-21 13:15
 3:31
3:31
2025-11-15 12:51
 2:37
2:37
2025-11-13 11:00
 2:44
2:44
2025-11-20 21:37
 3:14
3:14
2025-11-18 11:36
 3:40
3:40
2025-11-21 13:31
 2:37
2:37
2025-11-23 13:33
 2:11
2:11
2025-11-15 12:28
 3:31
3:31
2025-11-14 19:59
 2:41
2:41
2025-11-12 12:48
 2:30
2:30
2025-11-21 13:20
0/0
 1:46:45
1:46:45
2025-10-02 20:45
 1:54:23
1:54:23
2025-09-23 22:53
 1:33:34
1:33:34
2025-10-08 12:27
 1:52:27
1:52:27
2025-11-06 18:12
 1:44:15
1:44:15
2025-11-07 20:19
 2:36:13
2:36:13
2025-10-07 09:27
 1:42:30
1:42:30
2025-10-14 20:27
 1:34:35
1:34:35
2025-11-19 10:39
 1:35:11
1:35:11
2025-10-13 12:06
 1:55:08
1:55:08
2025-10-29 16:30
 1:56:34
1:56:34
2025-09-23 22:53
 2:02:20
2:02:20
2025-10-01 12:06
 1:54:40
1:54:40
2025-09-24 11:35
 1:56:59
1:56:59
2025-09-23 22:53
 2:09:55
2:09:55
2025-10-05 00:32
 1:50:35
1:50:35
2025-09-24 10:48
 2:32:29
2:32:29
2025-11-17 11:22
 1:38:22
1:38:22
2025-10-01 12:16
 1:39:56
1:39:56
2025-10-02 20:46
 1:32:16
1:32:16
2025-09-23 22:53
0/0
 7:04
7:04
2023-07-25 00:09
 11:04
11:04
2023-05-18 16:41
 11:20
11:20
2025-09-12 10:05
 3:28
3:28
2025-01-09 17:01
 1:05:35
1:05:35
2025-10-31 17:03
 11:27
11:27
2025-10-10 18:25
2021-09-22 22:40
 13:00
13:00
2024-12-02 13:15
2021-09-22 22:54
2021-09-22 21:52
 12:12
12:12
2024-11-29 14:21
 3:15
3:15
2025-06-10 13:56
 4:33
4:33
2024-12-17 16:56
 10:46
10:46
2022-06-07 11:02
2021-09-22 21:29
 7:01
7:01
2022-03-30 17:25
 45:30
45:30
2025-09-17 18:49
2021-09-22 22:45
 0:00
0:00
2025-11-24 23:04
 13:00
13:00
2024-11-28 16:19
0/0

